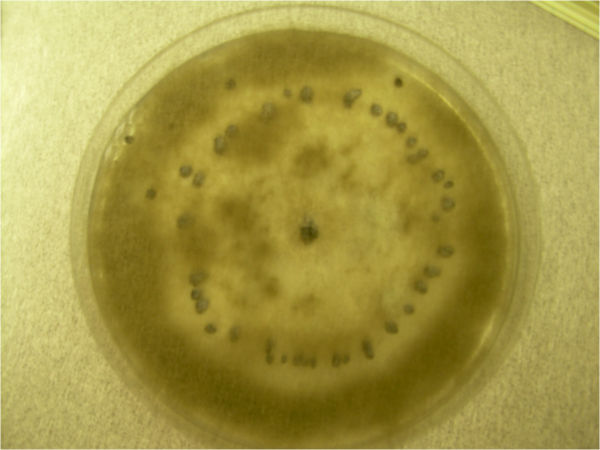

Ботритис серый
Ботри́тис се́рый, или пе́пельно-серый (лат. Botrýtis cinérea Pers., 1794) — несовершенная стадия (анаморфа) плесневого гриба, возбудителя серой гнили многих растений. Используется в виноделии при производстве вин позднего сбора. Совершенная стадия (телеоморфа) — Ботриоти́ния Фу́ккеля (Botryotinia fuckeliana).
Общие сведения
Таксономия
Современная научная классификация относит вид к царству Грибы, отделу Аскомицеты, классу Леоциомицеты, порядку Гелоциевые, семейству Склеротиниевые (Sclerotiniaceae)[4].
Гриб имеет две стадии жизненного цикла, для каждой из которых существует собственное научное название и синонимы.
- Анаморфа (бесполая стадия) — Botrytis cinerea. Название было впервые опубликовано Христианом Гендриком Персоном в 1794 году. К синонимам анаморфной стадии относят:
- Botrytis diospyri Brizi, 1901
- Botrytis gemella (Bonord.) Sacc., 1881
- Phymatotrichum gemellum Bonord., 1851
- Gonatobotryum sclerotigenum Van Warmelo, 1971
- Телеоморфа (половая стадия) — Botryotinia fuckeliana. Первоначально вид был описан Антоном де Бари в 1866 году как Peziza fuckeliana (это название является базионимом). В 1945 году американский миколог Герберт Хайс Уэтзел перенёс вид в род Botryotinia, установив современное название. К синонимам телеоморфной стадии относят:
- Peziza fuckeliana de Bary, 1866
- Sclerotinia fuckeliana (de Bary) Fuckel, 1870
Хотя половая стадия гриба известна, его традиционно относили к группе дейтеромицетов («несовершенных грибов»), для которых половой процесс не был описан.
Биология
Гриб живёт в почве и на растительных остатках в виде мицелия, некоторые формы образуют зимующие склероции. Анаморфная (бесполая) стадия покрывает субстрат густым серым или коричневатым налётом, состоящим из гиф и разветвлённых, древовидных конидиеносцев, дающих бесцветные или слабо дымчатые конидии. Конидии одноклеточные, различной формы (чаще овальные или почти сферические), размером 10-18×7-10 мкм, в массе сероватые. Конидиеносцы длиной до 2 мм, толщиной 16-30 мкм, прямые, разветвлённые, бесцветные или бледно-коричневые.
Склероции тёмные, до чёрного цвета, диаметром от 1 до 7 мм; их размер и форма сильно зависят от субстрата. Эта форма очень устойчива к внешним воздействиям и обеспечивает длительное сохранение живого гриба в неблагоприятных условиях, обычно на 2-3 года.
Вид очень изменчив, известно множество форм, характерных для различных природных субстратов и климатических зон, распространён по всему миру, но предпочитает влажный субтропический климат. Телеоморфная стадия известна для немногих разновидностей ботритиса серого.
Ботритис серый поражает большое число видов растений из примерно 45 семейств, но различные формы и расы паразитируют преимущественно на одном определённом виде и могут быть слабо патогенны для других растений. Например, форма, вызывающая кагатную гниль сахарной свёклы, почти не поражает ягоды винограда.
В умеренном климате развитие гриба начинается весной, с прорастания склероциев анаморфным или телеоморфным мицелием, заражение растений происходит конидиями или аскоспорами. Споры переносятся по воздуху, но заражению может способствовать высокая влажность или жидкая влага, поэтому оно происходит чаще в сырую погоду. Заражение часто начинается с появления небольших водянистых, быстро разрастающихся пятен[5]. Ботритис серый неспособен поражать живые клетки растений, необходимо наличие хотя бы небольших участков отмершей ткани. После развития на мёртвом субстрате происходит выделение токсинов, повреждающих соседнюю живую ткань и гриб таким способом распространяется по субстрату.
Наиболее характерный признак вызываемого грибом заболевания — серой гнили — появление обильного серого или пепельно-серого пушистого налёта, который состоит из конидиеносцев и конидий[6]. При прикосновении или порыве ветра споры легко отделяются, образуя облако пыли, что способствует быстрому распространению инфекции[6]. Поражённые ткани размягчаются, буреют и загнивают, приобретая вид мокрой гнили[7]. На стеблях и побегах могут образовываться сухие светло-бурые некротические пятна, которые, окольцовывая стебель, вызывают увядание и гибель всей части растения, расположенной выше.
- Виноград: на ягодах появляются бурые пятна, которые затем покрываются густым серым налётом. В особых погодных условиях (чередование влажных и сухих периодов) гриб вызывает так называемую «благородную гниль», при которой ягоды заизюмливаются, а содержание сахара в них концентрируется. Такой виноград используется для производства десертных вин, например, сотерна[8].
- Клубника (садовая земляника): на ягодах образуются бурые мокнущие пятна, быстро покрывающиеся серым пушистым налётом. Болезнь способна уничтожить значительную часть урожая, особенно в дождливую погоду[5].
- Томаты и огурцы: поражаются плоды и стебли, часто в местах повреждений (например, после удаления листьев). На плодах появляются серые водянистые пятна, а на стеблях — сухие некрозы[9].
- Цветочные культуры: гриб вызывает потемнение и увядание бутонов и цветков, на которых также развивается серый налёт[6].
Сам ботритис серый может поражаться гиперпаразитным грибом Gliocladium roseum[10], что может быть использовано как средство защиты. Этот гриб известен как эндосимбионт растений и почвенный сапротроф, у серой плесени он подавляет образование спор[11] и поражает мицелий.
Опасность
Вызывает многочисленные заболевания растений — кагатная гниль корнеплодов, серая гниль земляники, заболевания винограда, паслёновых, лука, цитрусовых и многих других растений. Часто поражает бобы, лён, гладиолусы, тепличные культуры, горох, салат[12].
Botrytis cinerea считается вторым по научной и экономической значимости фитопатогенным грибом в мире[13][14]. Ежегодные мировые экономические потери от вызываемой им серой гнили оцениваются в диапазоне от 10 до 100 миллиардов долларов США[13][15]. Ущерб складывается как из прямых потерь урожая, так и из затрат на борьбу с заболеванием. Ежегодные расходы на фунгициды для контроля Botrytis cinerea превышают 1 миллиард евро, что составляет около 8 % всего мирового рынка фунгицидов[15][13].
Для защиты земляники от поражения грибом на плантациях необходима хорошая вентиляция, плоды и листья стремятся изолировать от контакта с влажной почвой, мульчированием либо с помощью специальных полиэтиленовых покрытий для грунта.
Начато изучение генной структуры гриба, с целью снижения его патогенности и борьбы с ним[16].
Гриб Botrytis cinerea не считается патогеном, вызывающим инфекционные заболевания у людей со здоровой иммунной системой, однако его споры являются сильным воздушным аллергеном[17]. Вдыхание спор может провоцировать у предрасположенных лиц бронхиальную астму, аллергический ринит[17], а также редкую форму гиперчувствительного пневмонита, известную как «лёгкое виноградаря» (англ. winegrower's lung)[18].
Случаи инфекции, вызванной Botrytis cinerea, у людей крайне редки. В медицинской литературе описан единичный случай лёгочной инфекции у мужчины без выраженного иммунодефицита. Как правило, обнаружение гриба в дыхательных путях рассматривается как загрязнение образца или колонизация, не ведущая к развитию заболевания[19].
Применение в виноделии
Хотя в подавляющем большинстве случаев этот гриб рассматривают как достаточно опасный фитопатоген, существует по меньшей мере одно полезное применение штаммов Botrytis cinerea — в виноделии для получения более концентированного сырья с повышенной сахаристостью и изысканным ароматом[20].
В процессе созревания кожица ягод винограда становится всё более тонкой и осенью, когда температура воздуха снижается и повышается его влажность, Botrytis cinerea способствует образованию дырок в кожице винограда, через которые испаряется влага из сока ягоды, при этом накопленный сахар остаётся внутри. Ягода теряет массу, а концентрация сахара увеличивается. Развитие ботритиса на винограде очень опасно, так как сок ягоды становится незащищённым и внутрь могут попасть бактерии, ведущие к уксусному скисанию. Но если погодные условия благоприятствовали виноградарю и развитие ботритиса не повлекло развития болезней, из такого винограда может получиться сладкое вино позднего урожая.
Наиболее известны сладкие вина, произведённые из ботритизированного винограда на берегах Жиронды (сотерн) и Рейна — Мозеля (рислинг), а также в Токае.
Современные исследования
Биология Botrytis cinerea является предметом активных научных исследований, направленных на понимание механизмов его патогенности, генетического разнообразия и взаимодействия с растениями-хозяевами. С конца 2000-х годов, благодаря развитию геномных и молекулярно-биологических методов, был достигнут значительный прогресс в изучении этого фитопатогена.
В 2009 году были раскрыты молекулярные механизмы множественной лекарственной устойчивости (MDR) гриба, связанные с мутациями в гене транскрипционного фактора Mrr1, которые приводят к избыточной экспрессии ABC-транспортёров, «выкачивающих» фунгициды из клеток[21]. В этот же период был проведён масштабный анализ секретома, идентифицировавший 89 белков, выделяемых грибом для атаки на растение[22].
Ключевым событием 2010 года стала публикация геномной последовательности штамма B05.10, что предоставило научному сообществу мощный инструмент для дальнейших исследований[23]. В 2011 году сравнительный геномный анализ B. cinerea и родственного гриба Sclerotinia sclerotiorum выявил существенные различия в наборе мобильных генетических элементов, что может объяснять их разные адаптационные стратегии[24]. Также было установлено, что гриб способен активно манипулировать иммунной системой растений, подавляя защитные сигнальные пути, регулируемые салициловой и жасмоновой кислотами[25]. В этот же год был формально выделен новый вид — Botrytis pseudocinerea, часто встречающийся вместе с B. cinerea[26].
В 2013 году было сделано революционное открытие: B. cinerea использует механизм межцарственной РНК-интерференции, производя малые РНК, которые проникают в клетки растения и «отключают» гены, отвечающие за иммунитет[27]. В 2014 году были описаны новые виды, вызывающие серую гниль: Botrytis sinoviticola на винограде в Китае и Botrytis fragariae на клубнике в Германии, причём последний демонстрировал высокий уровень устойчивости к фунгицидам[28]. Исследование, проведённое в Германии с 2010 по 2015 год, выявило тревожную тенденцию к распространению штаммов с множественной устойчивостью, которые не уступали по жизнеспособности и агрессивности чувствительным штаммам[29].
В 2016 году был опубликован первый метилом полного генома гриба, который показал, что эпигенетическая регуляция (в частности, метилирование ДНК) играет важную роль в контроле его вирулентности[30]. В этом же году список известных растений-хозяев B. cinerea был расширен до более чем 1400 видов[31]. Важным достижением 2017 года стала публикация практически полной, «беспробельной» сборки генома штамма B05.10 с использованием современных технологий секвенирования, что позволило идентифицировать 18 хромосом[32]. Последующие годы были посвящены детальному изучению генов вирулентности и механизмов устойчивости, в том числе с помощью транскриптомного анализа, который выявил повышенную экспрессию генов мембранных транспортёров у резистентных штаммов.
Исследования последних лет сосредоточены на изучении специфических взаимодействий между штаммами патогена и генотипами растений-хозяев, а также на разработке инновационных методов борьбы. В 2021 году была выделена новая генетическая подгруппа гриба («группа B»), у которой отсутствует кластер генов, ответственный за синтез фитотоксина боциновой кислоты, что указывает на её специфическую адаптацию к определённым хозяевам[33]. Геномный анализ 2022 года показал, что штаммы, поражающие виноград и томаты, имеют существенные различия в наборах добавочных хромосом и малых РНК, что лежит в основе их специализации[34].
В качестве альтернативы химическим фунгицидам активно разрабатываются новые подходы, такие как биологический контроль с использованием бактерий, выделяющих летучие органические соединения[35], и РНК-интерференция для «отключения» жизненно важных генов гриба[36]. Исследования 2024 года раскрыли молекулярные механизмы, которые гриб использует для нейтрализации защитных соединений растений, таких как сапонины[37]. Сравнительный анализ исторических (собранных более 80 лет назад) и современных образцов гриба показал, что за это время он эволюционировал в сторону большей агрессивности и устойчивости к фунгицидам в ответ на интенсивное ведение сельского хозяйства[38].
Примечания
Литература
- Альмединген А. Н. Ботритис цинереа // Энциклопедический словарь Брокгауза и Ефрона : в 86 т. (82 т. и 4 доп.). — СПб., 1890—1907.
- Werner Rothmaler: Exkursionsflora für Deutschland. Band 1: Niedere Pflanzen, 3. Auflage. Fischer, Jena 1994. ISBN 3-334-60827-1
- Martijn Staats, Peter van Baarlen, Jan A. L. van Kan: Molecular Phylogeny of the Plant Pathogenic Genus Botrytis and the Evolution of Host Specificity. In: Molecular Biology and Evolution. 22, Nr. 2, 2005, S. 333—346. doi:10.1093/molbev/msi020
Ссылки
- Научные описания и изображения на сайте www.mycobank.org
- Botryotinia fuckeliana — таксономия
- Genome information for Botrytis cinerea
- Choquer M, Fournier E, Kunz C, Levis C, Pradier JM, Simon A, Viaud M (2007) Botrytis cinerea virulence factors: new insights into a necrotrophic and polyphageous pathogen FEMS Microbiol Lett. 277:1-10. Review
- TheWineDoctor.com
- Bortytis cinerea genetic variability
- Molecular Biology and Evolution vol. 22, no. 2, pp. 333—346